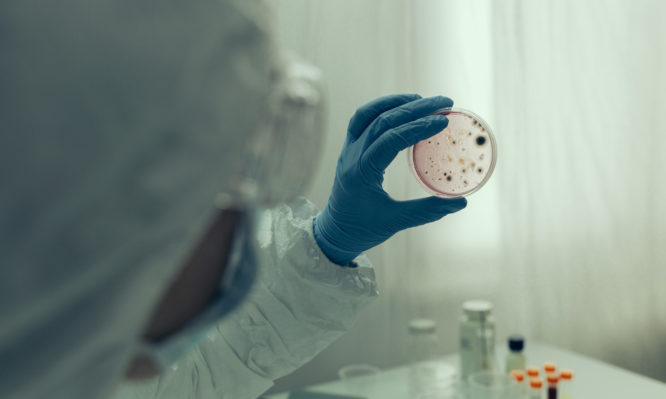

Συναγερμός για πανώλη στη Μαδαγασκάρη – 33 νεκροί μέχρι στιγμής
Θανατηφόρος βουβωνική και πνευμονική πανώλη έχει σκοτώσει τουλάχιστον 33 ανθρώπους στη Μαδαγασκάρη, ανακοίνωσαν αξιωματούχοι του Παγκόσμιου Οργανισμού Υγείας (ΠΟΥ).
Ο οργανισμός επιβεβαίωσε ότι περισσότεροι από 230 άνθρωποι έχουν μολυνθεί από την ιδιαίτερα μεταδοτική πανώλη. Οι αξιωματούχοι του προειδοποίησαν ότι ο κίνδυνος περαιτέρω εξάπλωσης της επιδημίας είναι υψηλός.
Έως στιγμής τα κρούσματα εντοπίζονται στην ανατολική και κεντρική Μαδαγασκάρη, όπου ο ΠΟΥ έχει ήδη αρχίσει την αποστολή επείγουσας βοήθειας και χρηματοδότησης.
Όπως ανακοίνωσε ο διεθνής οργανισμός, η πανώλη έχει ποσοστό θνησιμότητας 30-100% εάν δεν διαγνωσθεί και αντιμετωπιστεί εγκαίρως. Η πνευμονική μορφή της είναι πιο επικίνδυνη, διότι μεταδίδεται από άνθρωπο σε άνθρωπο με τον αέρα. Επομένως είναι πιο δύσκολος ο έλεγχός της (η βουβωνική πανώλη μεταδίδεται από τους ψύλλους).
Επιπλέον, είναι η πιο θανατηφόρος και πιο ταχέως εξελισσόμενη μορφή πανώλους.
Έκτακτα μέτρα από τον ΠΟΥ
Ωστόσο τόσο η βουβωνική όσο και η πνευμονική πανώλη μπορούν να αντιμετωπισθούν με συνηθισμένα αντιβιοτικά, εάν αυτά χορηγηθούν εγκαίρως. Γι’ αυτό τον λόγο, ο ΠΟΥ έστειλε ήδη σχεδόν 1,2 εκατομμύρια δόσεις αντιβιοτικών στο υπουργείο Υγείας της χώρας. Άμεσα θα παραδοθούν άλλες 244.000 δόσεις.
Οι δόσεις αυτές θα χρησιμοποιηθούν για θεραπευτικούς και προφυλακτικούς λόγους. Επαρκούν για τη θεραπεία έως 5.000 ασθενών και την προστασία έως 100.000 ατόμων που έχουν έρθει σε επαφή με αυτούς.
Όπως δήλωσε ο αξιωματούχος του ΠΟΥ Tarik Jašarević, «ο κίνδυνος εξάπλωσης της πανώλης στη Μαδαγασκάρη είναι υψηλός σε εθνικό επίπεδο. Έχουν ήδη καταγραφεί κρούσματα σε αρκετές πόλεις και η επιδημία μόλις άρχισε».
Τα περισσότερα από τα 231 κρούσματα που έχουν καταγραφεί είναι πνευμονική πανώλη. Δίχως αποτελεσματική θεραπεία είναι πάντοτε θανατηφόρος.
Η πανώλη προκαλείται από το βακτήριο Yersinia pestis (βάκιλος του Γέρσιν), το οποίο μεταδίδεται αρχικά στους ανθρώπους από τα τσιμπήματα ψύλλων που παρασιτούν σε άρρωστους μαύρους αρουραίους.
Στα βάθη των αιώνων έχουν καταγραφεί μεγάλες επιδημίες και πανδημίες πανώλους, με εκατομμύρια νεκρούς,. Τις τελευταίες δεκαετίες, όμως, η νόσος είναι ενδημική κυρίως:
- Στη Μαδαγασκάρη
- Στη Δημοκρατία του Κονγκό
- Στο Περού
Ωστόσο, δυνητικές φυσικές εστίες της υπάρχουν διάσπαρτες σε όλο κόσμο, σύμφωνα με τον ΠΟΥ. Η Μαδαγασκάρη τυπικά αντιμετωπίζει έως 400 κρούσματα τον χρόνο. Εφέτος, όμως, η πανώλη εξαπλώνεται με απρόσμενη ταχύτητα, έχοντας ήδη προσβάλλει κατοίκους στην πρωτεύουσά της και σε πολλές παράκτιες πόλεις, κατά τον κ. Jašarević.







